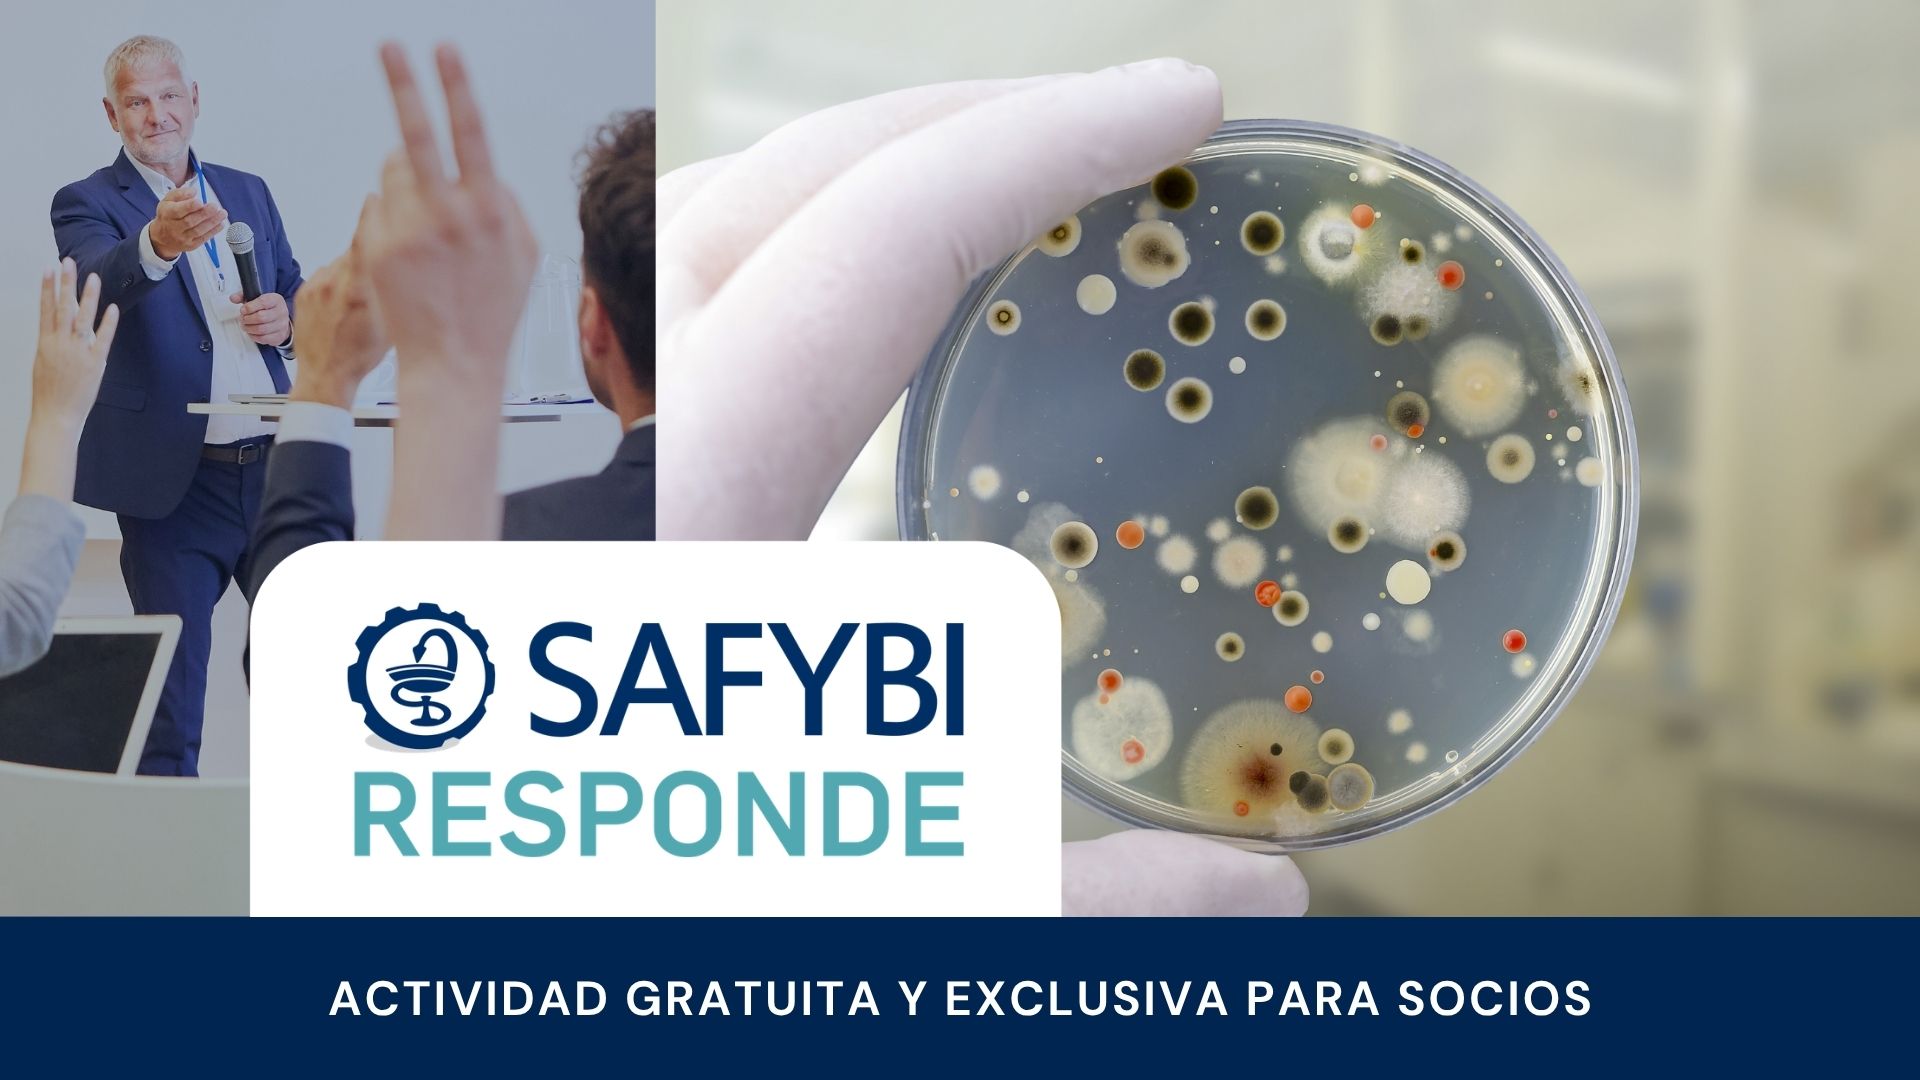

SAFYBI Responde
SAFYBI RESPONDE – Microbiología
MODALIDAD
FECHA
HORA
OBJETIVOS
Un espacio de discusión abierta entre los asociados para compartir consultas, resoluciones, y comentarios sobre nuestra actividad específica en el área de la microbiología. Es una linda actividad para compartir experiencias de una manera diferente, e interactiva, entre los miembros del comité y todos los participantes.
Por favor, envíanos las consultas puntuales sobre los temas a tratar, a completase en el formulario de inscripción, MUCHAS GRACIAS!!!
COORDINACIÓN:
Aixa Albornoz
DISERTANTES:

«Lic. en Ciencias Biológicas, Universidad CAECE. Farmacéutico, Universidad Argentina John F. Kennedy.
Curso de posgrado en Biología Molecular Aplicada a la Microbiología Clínica
Posgrado de Especialización en Control de Calidad Industrial – Quality Management – INCALIN (INTI
Certificación: Gestión de la Calidad y Competencia Técnica en Laboratorios de Calibración y Ensayos ISO/IEC 17025:2005.PTB (ALEMANIA)
”Quality Manager”, emitido por la Deutsche Gesellschaft für Qualität (DGQ Asociación Alemana para la Calidad).
Jefe de Microbiología de Laboratorio Roemmers S.A.I.C.F. Predio Luis Guillon. Manejo de auditorías ANMAT, COFEPRIS, INVIMA, DIGEMID, ANVISA, etc.
«

Bioquímica y estudiante de Farmacia de la Universidad de Buenos Aires, con más de ocho años de experiencia en control de calidad microbiológico en laboratorios nacionales y multinacionales de la industria cosmética y farmacéutica. Su trayectoria incluye la implementación de sistemas de calidad, análisis de productos y desarrollo de métodos microbiológicos. Cuenta además con experiencia en docencia universitaria como ayudante de cátedra en la Facultad de Farmacia y Bioquímica.

Farmacéutica y Licenciada en Ciencias Farmacéuticas de la Universidad Nacional de La Plata
(UNLP). Actualmente se desempeña como jefa de Microbiología de Planta La Plata, de
Laboratorios Bagó, y posee experiencia en Productos médicos y cosméticos.
Es integrante activa de la Sub comisión de Microbiología de la Farmacopea Nacional
Argentina.

Farmacéutica de la Universidad Argentina John F. Kennedy desde el año 2016
Diplomada en farmacia industrial de la Asociación de Farmacia y Bioquímica Industrial (SAFYBI).
Además es Técnica superior en biotecnología y análisis químico-biológico, de la Escuela Técnica ORT, 2003.
Actualmente se desempeña como Supervisora del laboratorio de Microbiología del Instituto Massone y es integrante del Comité de Expertos en Microbiología de SAFYBI.

Farmacéutico, de la Facultad de Farmacia y Bioquímica de la UBA, egresando en el año 2003. Además, se especializó en 2009, en Dirección de Operaciones farmacéuticas.
Su carrera laboral se inició en Ingeniería Ambiental, pero desde hace más de 20 años se dedica a la industria farmacéutica. Ha trabajado en la ANMAT, dependiente del Ministerio de Salud de la Nación, y en varias empresas farmacéuticas del sector privado. Actualmente es director técnico de un laboratorio, y director asociado de una consultora de brinda soporte a otras compañías del sector.
Microbióloga de la Universidad Nac. de Río Cuarto.
Posgrado en la Universidad de Belgrano: Quality Assurance.
Jefa de Microbiología Instituto Massone y Responsable de Validaciones de Control de Calidad, con tareas en: Participación de auditorías internas y externas (ANMAT, FDA, COFEPRIS, ANVISA PMDA, EMA), Verificación del cumplimiento del Plan de Monitoreo de aguas y redacción del resumen anual, Redacción y revisión de Protocolos de Validaciones de limpieza, analíticas, métodos microbiológicos, validaciones de equipos y Redacción y revisión de ARs (FMECA, FMEA, espina de pescado, GAP análisis, 5 porque, otros).
Farmacéutica (UJFK), Diplomada en Gestión y Operaciones en la Farmacia Industrial.
(I Salud). Posgrado en Desarrollo de Productos Farmacéuticos (UB) y Perito
Farmacéutico (UBA).
Con más de 15 años de experiencia en la Industria Farmacéutica, trabajó en Compañías farmacéuticas Nacionales e Internacionales en las áreas de Microbiología, Control de Calidad y Dirección Técnica. Es integrante y coordinadora del comité de expertos en Microbiología de SAFYBI.
Farmacéutica UBA, Pos grado en Formación de Auditores (UBA) y Diplomaturas en Farmacéutica Industrial (ISALUD y SAFYBI).
Formación profesional en el Departamento de Microbiología del INAME. Fiscalizadora de 1er Lote.
Desarrollo profesional en el área hospitalaria, magistral, oficinal, actualmente Jefe de Microbiología de Laboratorios Baliarda S.A.
Integrante de la Subcomisión de Microbiología de la Farmacopea Argentina. Miembro de Comisión Directiva y del Comité de Expertos de Microbiología de SAFyBI. Co autora de trabajos de investigación, docente en microbiología industrial en cursos y otros.
Bioquímica de grado con un Máster en Tecnología de los Alimentos realizado en la de la Universidad de Buenos Aires (UBA) y un Máster of Business and Management en la Universidad de WAIKATO, Nueva Zelanda.
Se desarrollo profesionalmente en laboratorios Nacionales y Multinacionales en las áreas de Control de Calidad fisicoquímico y microbiología. Además tiene experiencia en Inmunología clínica y consultoría profesional.
Bioquímica (FFyB – UBA). Y es Especialista en Calidad Industrial de los Alimentos (UNSAM).
Quality Manager (DGQ- EOQ). Evaluador de Laboratorios de Calibración y Ensayo según ISO 17025 (DGQ- EOQ).
Posgrado en Quality Management en la industria farmacéutica (Universidad de Belgrano) Posgrado de Farmacia Industrial (Safybi).
Miembro del Comité de Expertos en Microbiología (SAFYBI) y de la Comisión de Microbiología de Farmacopea Argentina.
Disertante en Jornadas y Congresos Científicos. Miembro de diversas Asociaciones profesionales. Docente universitario.
Antecedentes laborales: Inspector Anmat fase 3 Mercosur, a cargo de las áreas de control higiénico del departamento de microbiología y a cargo de Comercio exterior de INAME, entre otras funciones dentro de la Institución. Actualmente: Gerente de operaciones técnicas de laboratorio nacional Ultra Pharma S.A
Bioquímico y Farmacéutico.
Se ha desempeñado como docente de la cátedra de Microbiología de la Facultad de Farmacia y Bioquímica (UBA) en el ciclo de grado y postgrado, y en la carrera de Licenciatura en Alimentos, hasta llegar a Jefe.
Participó en trabajos de investigación y trabajó en el área de Microbiología Clínica.
A partir de 2006 trabaja en la industria farmacéutica, en la actualidad es Jefe de Control de Calidad de Laboratorios Siegfried.
Es miembro del comité de expertos de microbiología SAFYBI.
DIRIGIDO A
La actividad está dirigida a los técnicos, analistas, supervisores y aficionados en general a la Microbiología.
TEMARIO
El formato del abordaje de temas será libre y en respuesta a las consultas a realizar por los participantes.
Entre las los principales temas que se podrían consultar podrían estar los siguientes:
- Valoraciones biológicas (Antibióticos y endotoxinas)
- Microorganismos objetables
- Ensayos Microbiológicos (Control higiénico y esterilidad)
- Validación de sistemas críticos (Sistema de Agua)
- Validación de limpieza
- Monitoreos microbiológicos ambientales
- Validación de métodos
- Análisis de resultados
- Regulación y requisitos regulatorios
INVIERTE EN TU FORMACIÓN
| NO SOCIOS | AR$ 25.000 |

